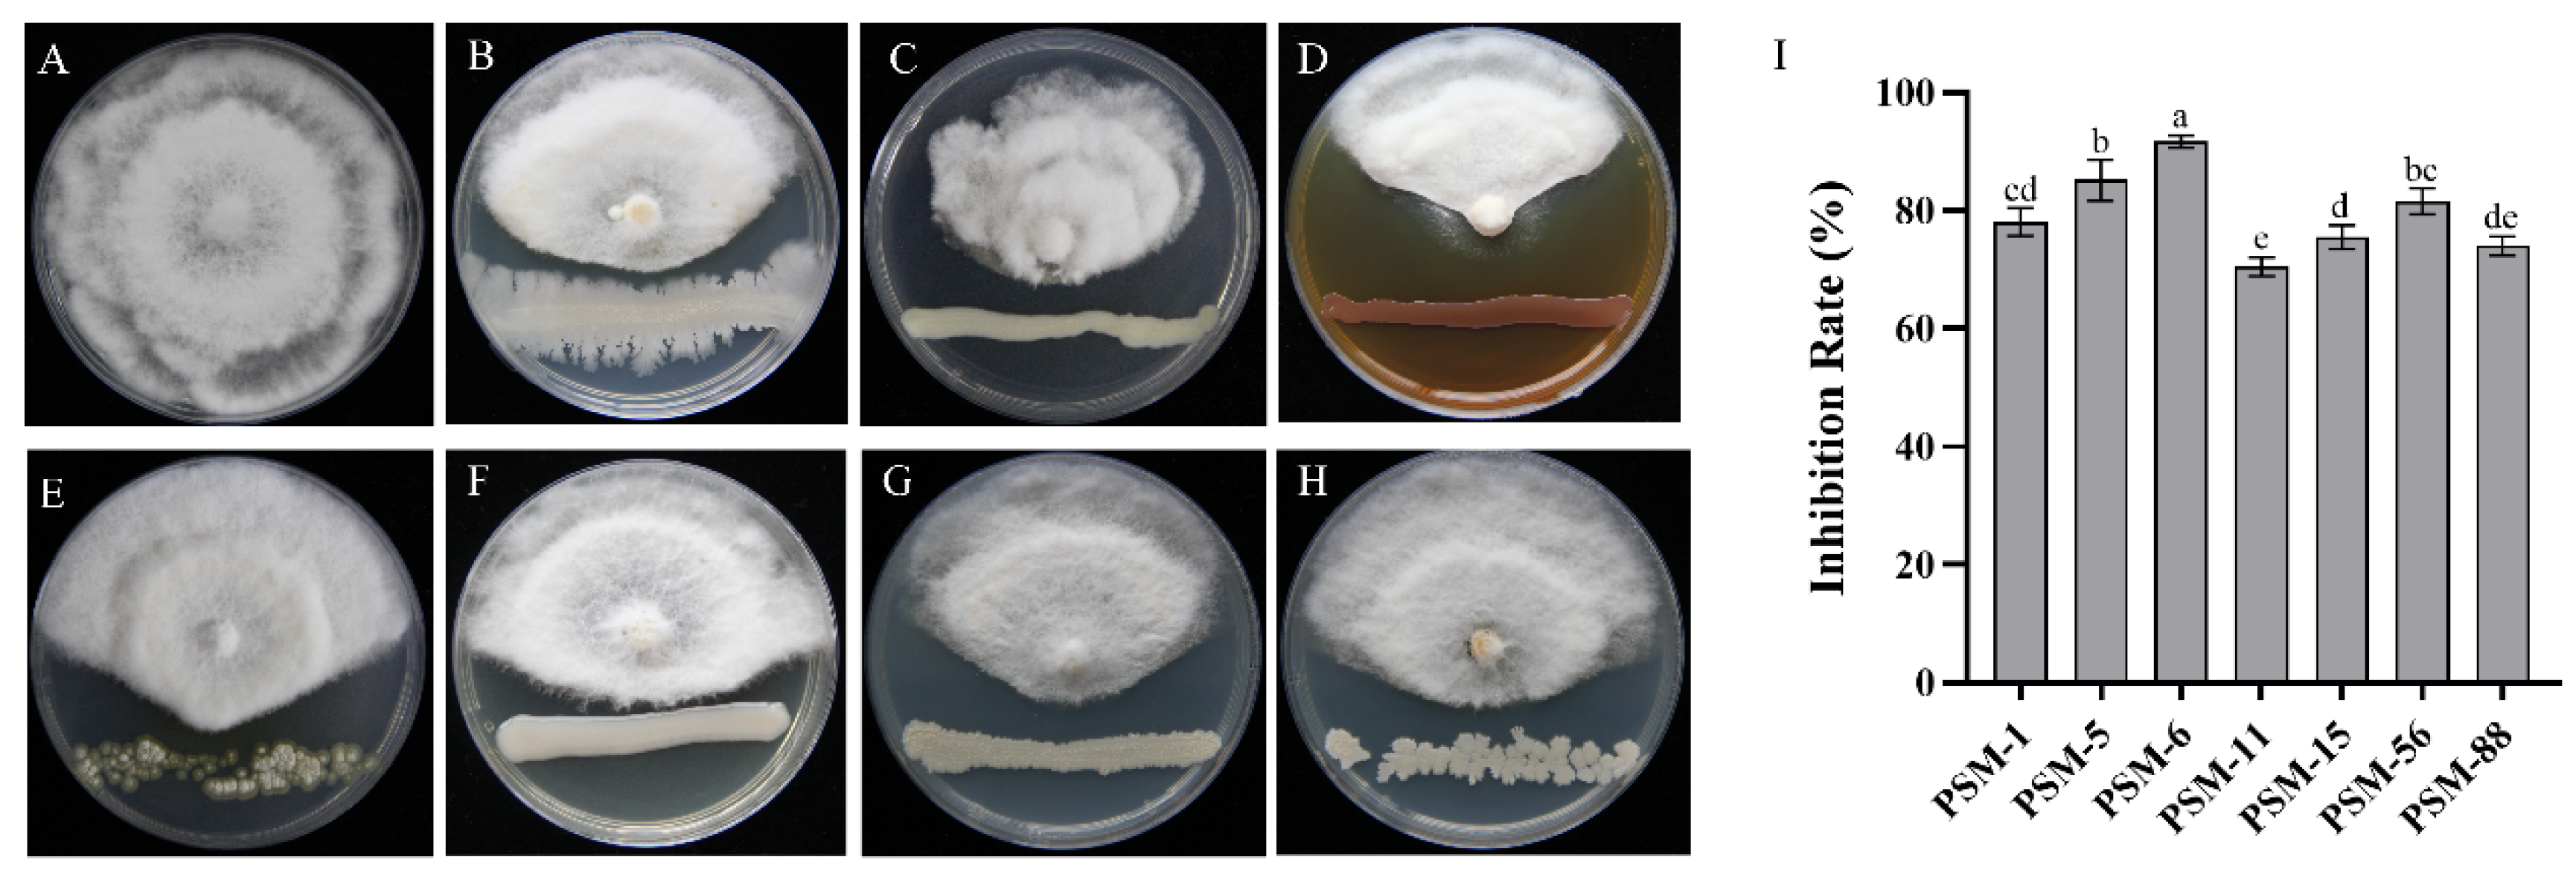
Forests 16 00650 g003 Forests 16 00650 g003
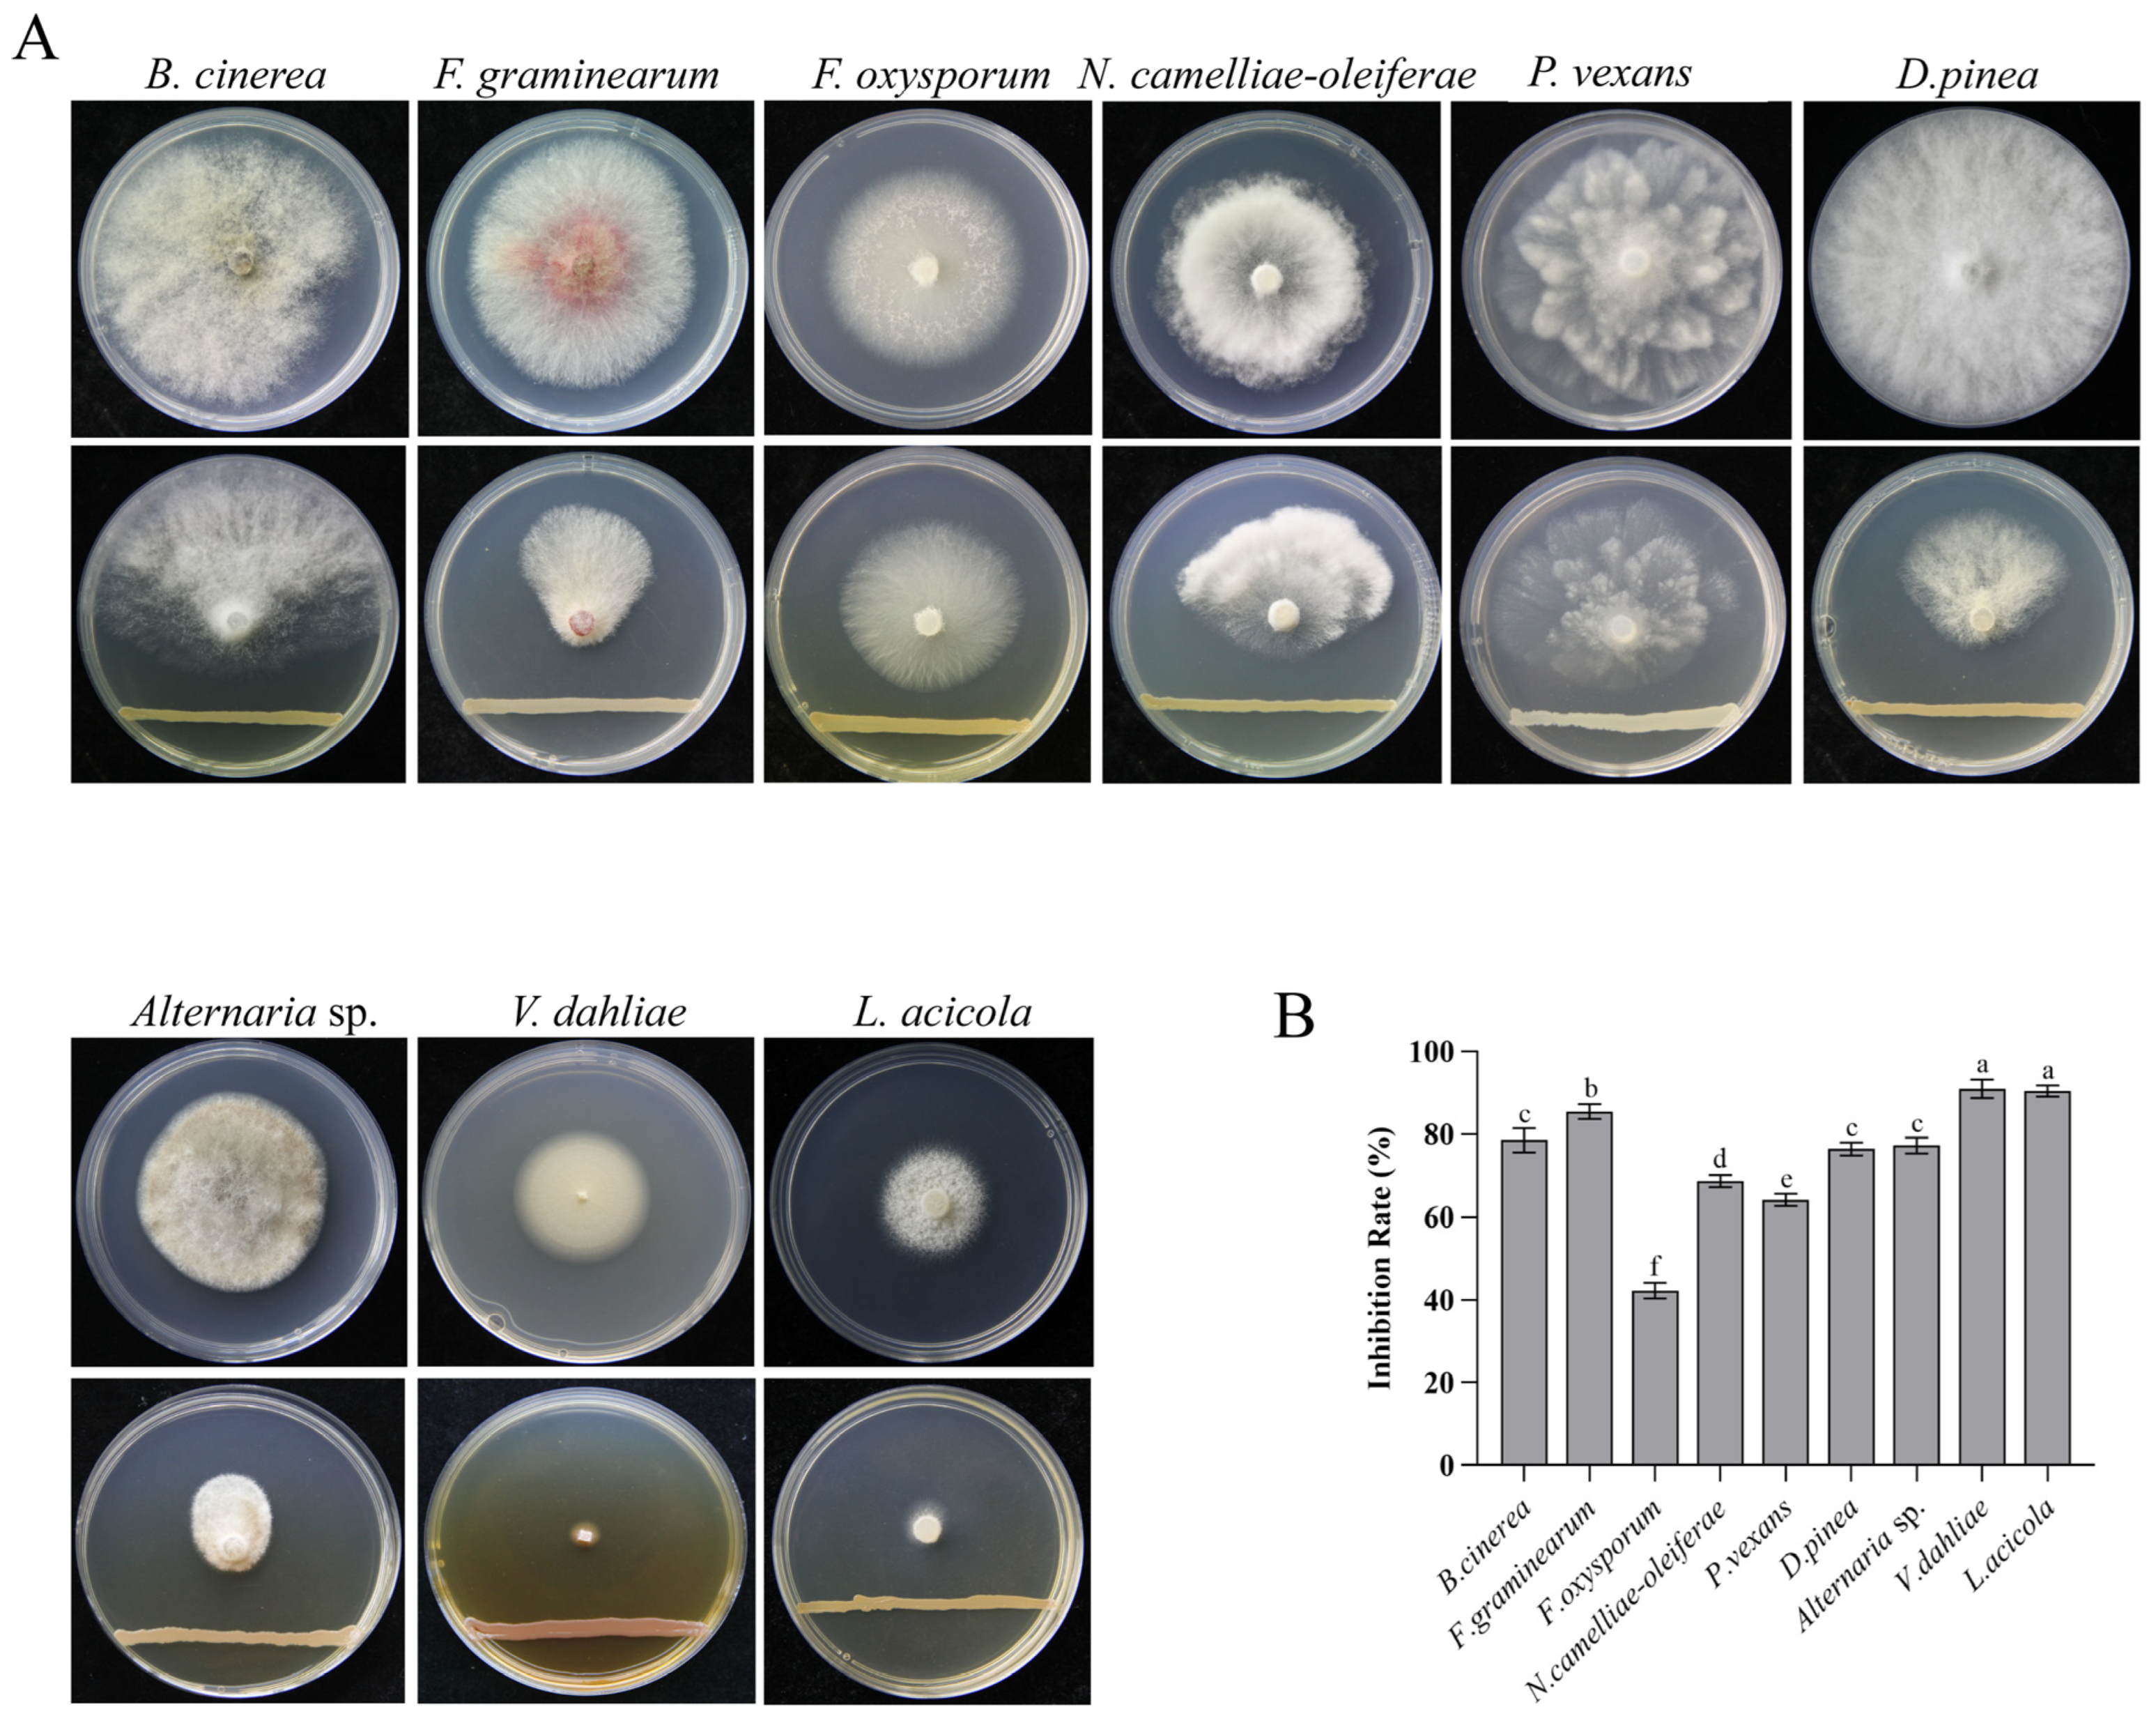
Forests 16 00650 g007 Forests 16 00650 g007

Endophytic Bacteria in Forest Protection: Pseudomonas silvicola Controls Pine Needle Blight in Masson Pine
Abstract
1. Introduction
2. Materials and Methods
2.1. Pathogen Isolation
2.2. Fungal Pathogenicity Test
2.3. Morphological and Molecular Identification of the Pathogen
2.4. Screening of Endophytic Bacteria from Pine Trees
2.5. Screening of Effective Endophytic Bacteria via a Plate Antagonism Assay
2.6. Morphological and Physicochemical Properties of Effective Endophytic Bacteria
2.7. Determination of the Taxonomic Status of Selected Endophytic Bacteria
2.8. Effects of Bacterial Volatile Organic Compounds (VOCs)
2.9. Effect of Sterile Bacterial Fermentation Supernatant
2.10. Effect of Bacterial Crude Extracts
2.11. Pot Experiment for the Disease Control Test
2.12. Antimicrobial Spectra of the Selected Bacteria
2.13. Data Analysis
3. Results
3.1. Disease Symptoms and Fungal Isolation
3.2. Pathogenicity Testing and Multilocus Phylogenetic Analyses
3.3. Screening and Identification of Endophytic Bacteria with Biocontrol Potential
3.4. Antifungal Component Testing of PSM-6
3.5. Biocontrol Efficacy of PSM-6 Against Pine Needle Blight in Potted Seedlings
3.6. Spectrum of the Antifungal Activity of PSM-6 Against Other Plant Pathogenic Fungi
4. Discussion
5. Conclusions
Supplementary Materials
Author Contributions
Funding
Data Availability Statement
Acknowledgments
Conflicts of Interest
References
- Yang, Z.; Zhao, J.; Ni, H.; Wang, H.; Zhou, B. Three Subtropical Species Adapt to Drought by Reallocating Biomass and Adjusting Root Architecture. Forests 2023, 14, 806. [Google Scholar] [CrossRef]
- Liu, J.; Gu, Z.; Shao, H.; Zhou, F.; Peng, S. N–P Stoichiometry in Soil and Leaves of Pinus massoniana Forest at Different Stand Ages in the Subtropical Soil Erosion Area of China. Environ. Earth Sci. 2016, 75, 1091. [Google Scholar] [CrossRef]
- Zhou, X.; Zhao, M.; Zhou, L.; Yang, G.; Huang, L.; Yan, C.; Huang, Q.; Ye, L.; Zhang, X.; Guo, L.; et al. Regionalization of Habitat Suitability of Masson’s Pine Based on Geographic Information System and Fuzzy Matter-Element Model. Sci. Rep. 2016, 6, 34716. [Google Scholar] [CrossRef] [PubMed]
- Li, R.; Zhu, L.; Chen, P.; Chen, Y.; Hao, Q.; Zhu, P.; Ji, K. Functional Characterization of PmDXR, a Critical Rate-Limiting Enzyme, for Turpentine Biosynthesis in Masson Pine (Pinus massoniana Lamb.). Int. J. Mol. Sci. 2024, 25, 4415. [Google Scholar] [CrossRef] [PubMed]
- Vicente, C.S.L.; Soares, M.; Faria, J.M.S.; Ramos, A.P.; Inácio, M.L. Insights into the Role of Fungi in Pine Wilt Disease. J. Fungi 2021, 7, 780. [Google Scholar] [CrossRef]
- Seo, S.T.; Park, M.J.; Park, J.H.; Shin, H.D. First Report of Brown Spot Needle Blight on Pinus thunbergii Caused by Lecanosticta Acicola in Korea. Plant Dis. 2012, 96, 914. [Google Scholar] [CrossRef]
- Hu, R.; Liang, J.; Xie, X.; Zhang, Y.; Zhang, X. Incidence of Pine Needle Blight and Its Relationship with Site Factors of Japanese Red Pine Forests in the Kunyushan Mountains, East China. Glob. Ecol. Conserv. 2020, 22, e00922. [Google Scholar] [CrossRef]
- Li, H.; Peng, B.-Y.; Xie, J.-Y.; Bai, Y.-Q.; Li, D.-W.; Zhu, L.-H. Pestalotiopsis jiangsuensis sp. nov. Causing Needle Blight on Pinus Massoniana in China. J. Fungi 2024, 10, 230. [Google Scholar] [CrossRef]
- Maharachchikumbura, S.S.N.; Hyde, K.D.; Groenewald, J.Z.; Xu, J.; Crous, P.W. Pestalotiopsis Revisited. Stud. Mycol. 2014, 79, 121–186. [Google Scholar] [CrossRef]
- Zheng, X.; Liu, X.; Li, X.; Quan, C.; Li, P.; Chang, X.; Gu, J.; Khaskheli, M.I.; Gong, G. Pestalotiopsis Species Associated with Blueberry Leaf Spots and Stem Cankers in Sichuan Province of China. Plant Dis. 2023, 107, 149–156. [Google Scholar] [CrossRef]
- Bhuiyan, M.A.B.; Islam, S.M.N.; Bukhari, M.A.I.; Kader, M.A.; Chowdhury, M.Z.H.; Alam, M.Z.; Abdullah, H.M.; Jenny, F. First Report of Pestalotiopsis microspora Causing Leaf Blight of Banana in Bangladesh. Plant Dis. 2022, 106, 1518. [Google Scholar] [CrossRef] [PubMed]
- Fiorenza, A.; Gusella, G.; Aiello, D.; Polizzi, G.; Voglmayr, H. Neopestalotiopsis siciliana sp. nov. and N. Rosae Causing Stem Lesion and Dieback on Avocado Plants in Italy. J. Fungi 2022, 8, 562. [Google Scholar] [CrossRef] [PubMed]
- Li, H.; Qiu, Y.; Yao, T.; Ma, Y.; Zhang, H.; Yang, X.; Li, C. Evaluation of Seven Chemical Pesticides by Mixed Microbial Culture (PCS-1): Degradation Ability, Microbial Community, and Medicago sativa Phytotoxicity. J. Hazard. Mater. 2020, 389, 121834. [Google Scholar] [CrossRef]
- Ayilara, M.S.; Adeleke, B.S.; Akinola, S.A.; Fayose, C.A.; Adeyemi, U.T.; Gbadegesin, L.A.; Omole, R.K.; Johnson, R.M.; Uthman, Q.O.; Babalola, O.O. Corrigendum: Biopesticides as an Alternative to Synthetic Pesticides: A Case for Nanopesticides, Phytopesticides and Microbial Pesticides. Front. Microbiol. 2024, 14, 1258968. [Google Scholar] [CrossRef]
- Hufbauer, R.A.; Roderick, G.K. Microevolution in Biological Control: Mechanisms, Patterns, and Processes. Biol. Control 2005, 35, 227–239. [Google Scholar] [CrossRef]
- Stenberg, J.A.; Sundh, I.; Becher, P.G.; Björkman, C.; Dubey, M.; Egan, P.A.; Friberg, H.; Gil, J.F.; Jensen, D.F.; Jonsson, M.; et al. When Is It Biological Control? A Framework of Definitions, Mechanisms, and Classifications. J. Pest. Sci. 2021, 94, 665–676. [Google Scholar] [CrossRef]
- Lipa, J.J. Biologiczne zwalczanie pasozytow i szkodnikow a srodowisko. Wiad. Parazytol. 1991, 37, 461–470. [Google Scholar]
- Batra, S.W.T. Biological Control in Agroecosystems. Science 1982, 215, 134–139. [Google Scholar] [CrossRef]
- Naranjo, S.E.; Ellsworth, P.C.; Frisvold, G.B. Economic Value of Biological Control in Integrated Pest Management of Managed Plant Systems. Annu. Rev. Entomol. 2015, 60, 621–645. [Google Scholar] [CrossRef]
- Wang, Z.; Chen, X.; Zhong, T.; Li, B.; Yang, Q.; Du, M.; Zalán, Z.; Kan, J. Bioeffector Pseudomonas fluorescens ZX Elicits Biosynthesis and Accumulation of Functional Ingredients in Citrus Fruit Peel: A Promising Strategy for a More Sustainable Crop. J. Agric. Food Chem. 2021, 69, 13810–13820. [Google Scholar] [CrossRef]
- Sorokina, T.A.; Mishustin, E.N. Distribution of Pseudomonas Fluorescent Bacteria in Soils and in the Root Zone of Plants. Biol. Bull. Acad. Sci. USSR 1978, 5, 584–589. [Google Scholar] [PubMed]
- Palleroni, N.J. The Pseudomonas Story. Environ. Microbiol. 2010, 12, 1377–1383. [Google Scholar] [CrossRef] [PubMed]
- Mavrodi, D.V.; Parejko, J.A.; Mavrodi, O.V.; Kwak, Y.; Weller, D.M.; Blankenfeldt, W.; Thomashow, L.S. Recent Insights into the Diversity, Frequency and Ecological Roles of Phenazines in Fluorescent Pseudomonas spp. Environ. Microbiol. 2013, 15, 675–686. [Google Scholar] [CrossRef]
- Abdelaziz, A.A.; Kamer, A.M.A.; Al-Monofy, K.B.; Al-Madboly, L.A. Pseudomonas aeruginosa’s Greenish-Blue Pigment Pyocyanin: Its Production and Biological Activities. Microb. Cell Fact. 2023, 22, 110. [Google Scholar] [CrossRef]
- Gross, H.; Loper, J.E. Genomics of Secondary Metabolite Production by Pseudomonas spp. Nat. Prod. Rep. 2009, 26, 1408–1446. [Google Scholar] [CrossRef]
- Hashimoto, M.; Hattori, K. Oxypyrrolnitrin: A Metabolite of Pseudomonas. Chem. Pharm. Bull. 1966, 14, 1314–1316. [Google Scholar] [CrossRef][Green Version]
- Gu, Q.; Qiao, J.; Wang, R.; Lu, J.; Wang, Z.; Li, P.; Zhang, L.; Ali, Q.; Khan, A.R.; Gao, X.; et al. The Role of Pyoluteorin from Pseudomonas protegens Pf-5 in Suppressing the Growth and Pathogenicity of Pantoea Ananatis on Maize. Int. J. Mol. Sci. 2022, 23, 6431. [Google Scholar] [CrossRef]
- Ma, Z.; Zhang, S.; Liang, J.; Sun, K.; Hu, J. Isolation and Characterization of a New Cyclic Lipopeptide Orfamide H from Pseudomonas protegens CHA0. J. Antibiot. 2020, 73, 179–183. [Google Scholar] [CrossRef]
- Guo, J.; Huang, X.; Lin, S.; Liu, Z.; Wang, H.; Gao, Q.; Zhou, H. Identification of Epicoccum latusicollum Causing Leaf Spot Disease on Bletilla striata in China. Crop Prot. 2024, 181, 106676. [Google Scholar] [CrossRef]
- Munakata, Y.; Spina, R.; Slezack-Deschaumes, S.; Genestier, J.; Hehn, A.; Laurain-Mattar, D. Screening of Endophytic Bacteria of Leucojum aestivum ‘Gravety Giant’ as a Potential Source of Alkaloids and as Antagonist to Some Plant Fungal Pathogens. Microorganisms 2022, 10, 2089. [Google Scholar] [CrossRef]
- Li, Z.; Li, H.; Zhang, J.; Zhang, S.; Zhao, Q.; Cheng, C.; Zhang, Y. Characterization of Fungal Species Isolated from Cankered Apple Barks Demonstrates the Alternaria alternata Causing Apple Canker Disease. J. Fungi 2024, 10, 536. [Google Scholar] [CrossRef] [PubMed]
- Morsy, A.A.; Elshahawy, I.E. Anthracnose of Lucky Bamboo Dracaena sanderiana Caused by the Fungus Colletotrichum dracaenophilum in Egypt. J. Adv. Res. 2016, 7, 327–335. [Google Scholar] [CrossRef] [PubMed]
- Lu, P.-K.; Liu, H.-H.; Chang, H.-X. First Report of Corynespora cassiicola Causing Target Spot on Soybean in Taiwan. Plant Dis. 2021, 105, 3753. [Google Scholar] [CrossRef] [PubMed]
- Ji, Y.; Wang, J.; Liu, Y.; Liu, S.; Jiang, X.; Huang, H. Isolation and Identification of Postharvest Rot Pathogens in Citrus × tangelo and Their Potential Inhibition with Acidic Electrolyzed Water. Food Environ. Virol. 2024, 16, 409–421. [Google Scholar] [CrossRef]
- Zhang, Y.-Y.; Zhang, T.; Li, H.-Y.; Zheng, R.; Ren, J.; Yang, Q.; Jiang, N. Nigrospora humicola (Apiosporaceae, Amphisphaeriales), a New Fungus from Soil in China. Diversity 2024, 16, 118. [Google Scholar] [CrossRef]
- Luo, X.-X.; Liao, M.-G.; Zhang, K.; Castaneda-Ruiz, R.F.; Ma, J.; Xu, Z.-H. Morphological and Phylogenetic Analyses Reveal Eight Novel Species of Pestalotiopsis (Sporocadaceae, Amphisphaeriales) from Southern China. MycoKeys 2024, 109, 207–238. [Google Scholar] [CrossRef]
- Zafri, A.S.; Muhamad, R.; Wahab, A.; Mokhtar, A.S.; Mohd Hata, E. First Report of Leaf Blight on Parthenium hysterophorus Caused by Nigrospora sphaerica in Malaysia. Plant Dis. 2021, 105, 3297. [Google Scholar] [CrossRef]
- Xiang, C.-Y.; Gao, F.; Jakovlić, I.; Lei, H.-P.; Hu, Y.; Zhang, H.; Zou, H.; Wang, G.-T.; Zhang, D. Using PhyloSuite for Molecular Phylogeny and Tree-Based Analyses. Imeta 2023, 2, e87. [Google Scholar] [CrossRef]
- Nguyen, L.-T.; Schmidt, H.A.; von Haeseler, A.; Minh, B.Q. IQ-TREE: A Fast and Effective Stochastic Algorithm for Estimating Maximum-Likelihood Phylogenies. Mol. Biol. Evol. 2015, 32, 268–274. [Google Scholar] [CrossRef]
- Tao, Y.; Quan, X.; Khokhar, I.; Anjum, T.; Song, H.; Mukhtar, I. First Report of Pseudopestalotiopsis theae Causing Leaf Spot of Date Palm (Phoenix dactylifera) in China. Plant Dis. 2020, 105, 508. [Google Scholar] [CrossRef]
- Shen, H.; Li, X.; Li, Z. Detecting and Identifying Pathogens and Antagonistic Bacteria Associated with Ginkgo biloba Leaf Spot Disease. Front. Microbiol. 2024, 15, 1346318. [Google Scholar] [CrossRef] [PubMed]
- Jung, B.-N.; Park, J.-H.; Lee, S.-H.; Shin, H.-D. First Report of Rhytisma sp. Associated with Tar Spots on Ilex cornuta. Korean J. Mycol. 2020, 48, 63–67. [Google Scholar] [CrossRef]
- Sa, R.; He, S.; Han, D.; Liu, M.; Yu, Y.; Shang, R.; Song, M. Isolation and Identification of a New Biocontrol Bacteria against Salvia miltiorrhiza Root Rot and Optimization of Culture Conditions for Antifungal Substance Production Using Response Surface Methodology. BMC Microbiol. 2022, 22, 231. [Google Scholar] [CrossRef] [PubMed]
- Saidi, N.; Kouki, S.; M’Hiri, F.; Hajlaoui, M.R.; Mahrouk, M.; Ou-Zari, H.; Jedidi, N.; Hasseni, A. Characterization and Selection of Bacillus sp. Strains, Effective Biocontrol Agents against Fusarium oxysporum f. sp. Radicis-lycopersici, the Causal Agent of Fusarium Crown and Root Rot in Tomato. Ann. Microbiol. 2009, 59, 191–198. [Google Scholar] [CrossRef]
- Panebianco, S.; Lombardo, M.F.; Anzalone, A.; Musumarra, A.; Pellegriti, M.G.; Catara, V.; Cirvilleri, G. Epiphytic and Endophytic Microorganisms Associated to Different Cultivar of Tomato Fruits in Greenhouse Environment and Characterization of Beneficial Bacterial Strains for the Control of Post-Harvest Tomato Pathogens. Int. J. Food Microbiol. 2022, 379, 109861. [Google Scholar] [CrossRef]
- Moyes, R.B.; Reynolds, J.; Breakwell, D.P. Differential Staining of Bacteria: Gram Stain. Curr. Protoc. Microbiol. 2009, 15, A.3C.1–A.3C.8. [Google Scholar] [CrossRef]
- Guerrero, R. Bergey’s Manuals and the Classification of Prokaryotes. Int. Microbiol. 2001, 4, 103–109. [Google Scholar] [CrossRef]
- Kuchar, K.W. Der Formenkreis von Pseudomonas punctata (Zimm.) Chester; zur Fassung der Gattung Pseudomonas in Bergey’s Manual. Zentralbl Bakteriol. Orig. 1954, 160, 511–517. [Google Scholar]
- Miller, D.N.; Bryant, J.E.; Madsen, E.L.; Ghiorse, W.C. Evaluation and Optimization of DNA Extraction and Purification Procedures for Soil and Sediment Samples. Appl. Environ. Microbiol. 1999, 65, 4715–4724. [Google Scholar] [CrossRef]
- Clarridge, J.E. Impact of 16S rRNA Gene Sequence Analysis for Identification of Bacteria on Clinical Microbiology and Infectious Diseases. Clin. Microbiol. Rev. 2004, 17, 840–862. [Google Scholar] [CrossRef]
- Li, X.; Wang, X.; Yang, H.; Gao, X.; Cui, Z. Application of gyrB in the Identification of Closely Related Bacteria—A Review. Wei Sheng Wu Xue Bao = Acta Microbiol. Sin. 2008, 48, 701–706. [Google Scholar]
- Oztas Gulmus, E.; Gormez, A. Identification and Characterization of Novel Thermophilic Bacteria from Hot Springs, Erzurum, Turkey. Curr. Microbiol. 2020, 77, 979–987. [Google Scholar] [CrossRef] [PubMed]
- Kai, M.; Vespermann, A.; Piechulla, B. The Growth of Fungi and Arabidopsis Thaliana Is Influenced by Bacterial Volatiles. Plant Signal Behav. 2008, 3, 482–484. [Google Scholar] [CrossRef]
- Jayawardena, R.S.; Zhang, W.; Liu, M.; Maharachchikumbura, S.S.N.; Zhou, Y.; Huang, J.; Nilthong, S.; Wang, Z.; Li, X.; Yan, J.; et al. Identification and Characterization of Pestalotiopsis-like Fungi Related to Grapevine Diseases in China. Fungal Biol. 2015, 119, 348–361. [Google Scholar] [CrossRef]
- Steyaert, R.L. Contribution à l’étude Monographique de Pestalotia de Not. et Monochaetia Sacc. (Truncatella gen. nov. et Pestalotiopsis gen. nov.). Bull. Jard. Bot. L’état A Brux. 1949, 19, 285–347. [Google Scholar] [CrossRef]
- Tejesvi, M.V.; Tamhankar, S.A.; Kini, K.R.; Rao, V.S.; Prakash, H.S. Phylogenetic Analysis of Endophytic Pestalotiopsis Species from Ethnopharmaceutically Important Medicinal Trees. Fungal Divers. 2009, 38, 167. [Google Scholar]
- Jeewon, R.; Liew, E.C.Y.; Hyde, K.D. Phylogenetic Relationships of Pestalotiopsis and Allied Genera Inferred from Ribosomal DNA Sequences and Morphological Characters. Mol. Phylogenet. Evol. 2002, 25, 378–392. [Google Scholar] [CrossRef]
- Ma, X.-Y.; Maharachchikumbura, S.S.N.; Chen, B.-W.; Hyde, K.D.; Mckenzie, E.H.C.; Chomnunti, P.; Kang, J.-C. Endophytic Pestalotiod Taxa in Dendrobium Orchids. Phytotaxa 2019, 419, 268–286. [Google Scholar] [CrossRef]
- Tian, L.; Zhang, Y.; Yang, H.; Zhao, Q.; Qiu, H.; Xu, J.; Qin, C. Taxonomic Description and Complete Genome Sequencing of Pseudomonas silvicola sp. Nov. Isolated from Cunninghamia laceolata. Forests 2023, 14, 1089. [Google Scholar] [CrossRef]
- Lugtenberg, B.J.; Dekkers, L.C. What Makes Pseudomonas Bacteria Rhizosphere Competent? Environ. Microbiol. 1999, 1, 9–13. [Google Scholar] [CrossRef]
- Goldberg, J.B. Pseudomonas: Global Bacteria. Trends Microbiol. 2000, 8, 55–57. [Google Scholar] [CrossRef] [PubMed]
- Preston, G.M. Plant Perceptions of Plant Growth-Promoting Pseudomonas. Philos. Trans. R. Soc. Lond. B Biol. Sci. 2004, 359, 907–918. [Google Scholar] [CrossRef] [PubMed]
- Meyer, J.M. Pyoverdines: Pigments, Siderophores and Potential Taxonomic Markers of Fluorescent Pseudomonas Species. Arch. Microbiol. 2000, 174, 135–142. [Google Scholar] [CrossRef]
- Kong, P.; Hong, C. Evaluation of 1021Bp, a Close Relative of Pseudomonas eucalypticola, for Potential of Plant Growth Promotion, Fungal Pathogen Suppression and Boxwood Blight Control. BMC Microbiol. 2024, 24, 346. [Google Scholar] [CrossRef]
- Mokhtari, S.; Chavez, M.; Ali, A. First Report of Fusarium oxysporum f. sp. Vasinfectum Causing Fusarium Wilt of Cotton in Kansas, U.S.A. Plant Dis. 2022, 107, 1239. [Google Scholar] [CrossRef]
- Tubby, K.; Adamčikova, K.; Adamson, K.; Akiba, M.; Barnes, I.; Boroń, P.; Bragança, H.; Bulgakov, T.; Burgdorf, N.; Capretti, P.; et al. The Increasing Threat to European Forests from the Invasive Foliar Pine Pathogen, Lecanosticta acicola. Ecol. Manag. 2023, 536, 120847. [Google Scholar] [CrossRef]
- Iakovleva, L.M.; Pastushenko, L.T.; Simonovich, I.D.; Stepaniuk, V.V. Dissotsiatsiia nekotorykh fitopatogennykh bakterii roda Pseudomonas. Mikrobiol. Zh 1978, 40, 596–599. [Google Scholar]
- Pascual, J.; García-López, M.; Carmona, C.; Sousa, T.d.S.; de Pedro, N.; Cautain, B.; Martín, J.; Vicente, F.; Reyes, F.; Bills, G.F.; et al. Pseudomonas soli sp. Nov., a Novel Producer of Xantholysin Congeners. Syst. Appl. Microbiol. 2014, 37, 412–416. [Google Scholar] [CrossRef]
- Wang, Y.-N.; He, W.-H.; He, H.; Du, X.; Jia, B.; Zeng, Z.-P.; An, M.-L.; Chen, G.-C. Pseudomonas nitritireducens sp. Nov., a Nitrite Reduction Bacterium Isolated from Wheat Soil. Arch. Microbiol. 2012, 194, 809–813. [Google Scholar] [CrossRef]
- Shochat, E.; Hermoni, I.; Cohen, Z.; Abeliovich, A.; Belkin, S. Bromoalkane-Degrading Pseudomonas Strains. Appl. Environ. Microbiol. 1993, 59, 1403–1409. [Google Scholar] [CrossRef]
- Biessy, A.; Filion, M. Phenazines in Plant-Beneficial Pseudomonas spp.: Biosynthesis, Regulation, Function and Genomics. Environ. Microbiol. 2018, 20, 3905–3917. [Google Scholar] [CrossRef] [PubMed]
- Löser, T.B.; Mescher, M.C.; De Moraes, C.M.; Maurhofer, M. Effects of Root-Colonizing Fluorescent Pseudomonas Strains on Arabidopsis Resistance to a Pathogen and an Herbivore. Appl. Environ. Microbiol. 2021, 87, e0283120. [Google Scholar] [CrossRef] [PubMed]
- Lurthy, T.; Gerin, F.; Rey, M.; Mercier, P.-E.; Comte, G.; Wisniewski-Dyé, F.; Prigent-Combaret, C. Pseudomonas Produce Various Metabolites Displaying Herbicide Activity against Broomrape. Microbiol. Res. 2025, 290, 127933. [Google Scholar] [CrossRef] [PubMed]
- Liu, Y.; Zhou, Y.; Qiao, J.; Yu, W.; Pan, X.; Zhang, T.; Liu, Y.; Lu, S.-E. Phenazine-1-Carboxylic Acid Produced by Pseudomonas chlororaphis YL-1 Is Effective against Acidovorax citrulli. Microorganisms 2021, 9, 2012. [Google Scholar] [CrossRef]
- Silby, M.W.; Winstanley, C.; Godfrey, S.A.C.; Levy, S.B.; Jackson, R.W. Pseudomonas Genomes: Diverse and Adaptable. FEMS Microbiol. Rev. 2011, 35, 652–680. [Google Scholar] [CrossRef]
- Espinosa-Urgel, M.; Ramos-González, M.I. Becoming Settlers: Elements and Mechanisms for Surface Colonization by Pseudomonas putida. Environ. Microbiol. 2023, 25, 1575–1593. [Google Scholar] [CrossRef]
- Basiru, S.; Ait Si Mhand, K.; Hijri, M. Disentangling Arbuscular Mycorrhizal Fungi and Bacteria at the Soil-Root Interface. Mycorrhiza 2023, 33, 119–137. [Google Scholar] [CrossRef]
- Pršić, J.; Ongena, M. Elicitors of Plant Immunity Triggered by Beneficial Bacteria. Front. Plant Sci. 2020, 11, 594530. [Google Scholar] [CrossRef]

| Disease Grade | Classification Criteria | Representative Value |
|---|---|---|
| 1 | No symptoms | 0 |
| 2 | Less than 25% of leaves affected | 1 |
| 3 | 25%–50% of leaves affected | 2 |
| 4 | 50%–75% of leaves affected | 3 |
| 5 | More than 75% of leaves affected | 4 |
| Physiological Characteristic | PSM-6 |
|---|---|
| Voges-Proskauer (V-P) reaction | − |
| cellulase degradation | − |
| indole-3-acetic acid (IAA) production | − |
| gelatin liquefaction | − |
| inorganic phosphate solubilization | − |
| nitrogen fixation assay | − |
| methyl red | + |
| catalase test | + |
| amylase production | + |
| potassium solubilization | + |
| organic phosphorus solubilization | + |
| siderophore production | + |
Disclaimer/Publisher’s Note: The statements, opinions and data contained in all publications are solely those of the individual author(s) and contributor(s) and not of MDPI and/or the editor(s). MDPI and/or the editor(s) disclaim responsibility for any injury to people or property resulting from any ideas, methods, instructions or products referred to in the content. |
© 2025 by the authors. Licensee MDPI, Basel, Switzerland. This article is an open access article distributed under the terms and conditions of the Creative Commons Attribution (CC BY) license (https://creativecommons.org/licenses/by/4.0/).
Share and Cite
Wang, X.-Y.; Xu, F.; Li, M.; Latif, M.F.; Li, H.; Chen, F. Endophytic Bacteria in Forest Protection: Pseudomonas silvicola Controls Pine Needle Blight in Masson Pine. Forests 2025, 16, 650. https://doi.org/10.3390/f16040650
Wang X-Y, Xu F, Li M, Latif MF, Li H, Chen F. Endophytic Bacteria in Forest Protection: Pseudomonas silvicola Controls Pine Needle Blight in Masson Pine. Forests. 2025; 16(4):650. https://doi.org/10.3390/f16040650
Chicago/Turabian StyleWang, Xin-Yi, Fan Xu, Min Li, Muhammad Faizan Latif, Huan Li, and Fengmao Chen. 2025. "Endophytic Bacteria in Forest Protection: Pseudomonas silvicola Controls Pine Needle Blight in Masson Pine" Forests 16, no. 4: 650. https://doi.org/10.3390/f16040650
APA StyleWang, X.-Y., Xu, F., Li, M., Latif, M. F., Li, H., & Chen, F. (2025). Endophytic Bacteria in Forest Protection: Pseudomonas silvicola Controls Pine Needle Blight in Masson Pine. Forests, 16(4), 650. https://doi.org/10.3390/f16040650

